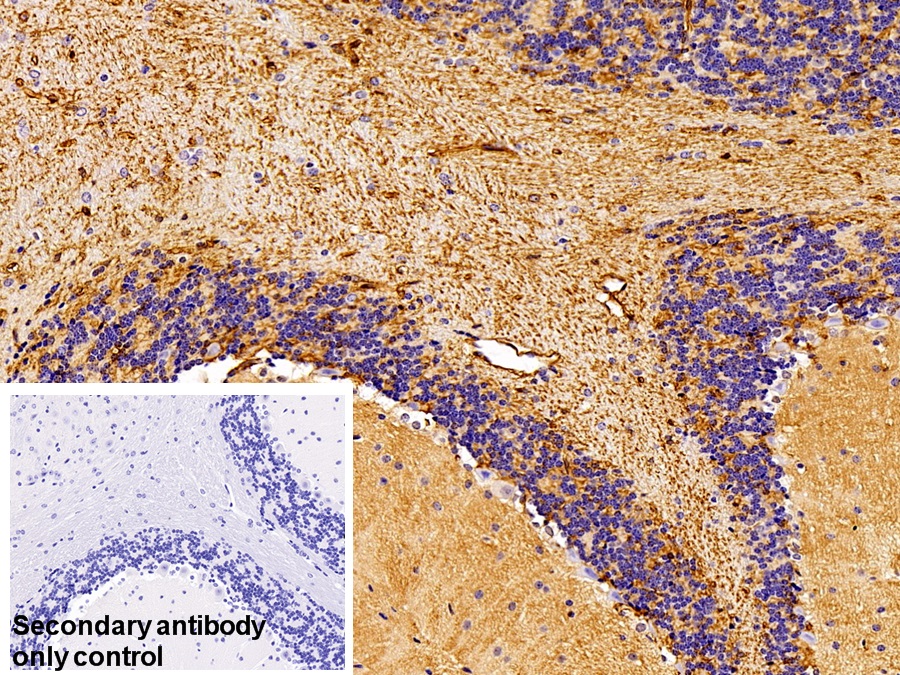

Polyclonal Antibody to Aquaporin 4 (AQP4)
HMIWC2; MIWC; WCH4; Mercurial-insensitive water channel
- Product No.PAA582Mu01
- Organism SpeciesMus musculus (Mouse) Same name, Different species.
- SourcePolyclonal antibody preparation
- HostRabbit
- Potencyn/a
- Ig Type IgG
- PurificationAntigen-specific affinity chromatography followed by Protein A affinity chromatography
- LabelNone
- Immunogen RPA582Mu01-Recombinant Aquaporin 4 (AQP4)
- Buffer Formulation0.01M PBS, pH7.4, containing 0.05% Proclin-300, 50% glycerol.
- TraitsLiquid
- Concentration0.5mg/ml
- Organism Species Moren/a
- ApplicationsWB; IHC
If the antibody is used in flow cytometry, please check FCM antibodies. - DownloadInstruction Manual
- UOM 20µl100µl 200µl 1ml 10ml
- FOB
US$ 97
US$ 227
US$ 324
US$ 810
US$ 3240
For more details, please contact local distributors!
SPECIFITY
The antibody is a rabbit polyclonal antibody raised against AQP4. It has been selected for its ability to recognize AQP4 in immunohistochemical staining and western blotting.
USAGE
Western blotting: 0.01-2µg/mL
Immunohistochemistry: 5-20µg/mL
Immunocytochemistry: 5-20µg/mL
Optimal working dilutions must be determined by end user.
STORAGE
Store at 4°C for frequent use. Stored at -20°C in a manual defrost freezer for two year without detectable loss of activity. Avoid repeated freeze-thaw cycles.
STABILITY
The thermal stability is described by the loss rate. The loss rate was determined by accelerated thermal degradation test, that is, incubate the protein at 37°C for 48h, and no obvious degradation and precipitation were observed. The loss rate is less than 5% within the expiration date under appropriate storage condition.
GIVEAWAYS
INCREMENT SERVICES
-
 Antibody Labeling Customized Service
Antibody Labeling Customized Service
-
 Protein A/G Purification Column
Protein A/G Purification Column
-
 Staining Solution for Cells and Tissue
Staining Solution for Cells and Tissue
-
 Positive Control for Antibody
Positive Control for Antibody
-
 Tissue/Sections Customized Service
Tissue/Sections Customized Service
-
 Phosphorylated Antibody Customized Service
Phosphorylated Antibody Customized Service
-
 Western Blot (WB) Experiment Service
Western Blot (WB) Experiment Service
-
 Immunohistochemistry (IHC) Experiment Service
Immunohistochemistry (IHC) Experiment Service
-
 Immunocytochemistry (ICC) Experiment Service
Immunocytochemistry (ICC) Experiment Service
-
 Flow Cytometry (FCM) Experiment Service
Flow Cytometry (FCM) Experiment Service
-
 Immunoprecipitation (IP) Experiment Service
Immunoprecipitation (IP) Experiment Service
-
 Immunofluorescence (IF) Experiment Service
Immunofluorescence (IF) Experiment Service
-
 Buffer
Buffer
-
 DAB Chromogen Kit
DAB Chromogen Kit
-
 SABC Kit
SABC Kit
-
 Long-arm Biotin Labeling Kit
Long-arm Biotin Labeling Kit
-
 Real Time PCR Experimental Service
Real Time PCR Experimental Service
| Magazine | Citations |
| Neuroscience Letters | Aquaporins AQP1 and AQP4 in the cerebrospinal fluid of bacterial meningitis patients ScienceDirect: S0304394011012341 |
| Neurology | Astrocytic damage is far more severe than demyelination in NMO Neurology: 208 |
| Fluids and Barriers of the CNS | Aquaporin-4 expression in the cerebrospinal fluid in congenital human hydrocephalus PubMed: PMC3651869 |
| Neuropeptides | Melanocortin MC4 receptor agonists alleviate brain damage in abdominal compartment syndrome in the rat PubMed: 25616531 |
| Human & Experimental Toxicology | Novel effect of Daflon and low-dose γ-radiation in modulation of thioacetamide-induced hepatic encephalopathy in male albino rats Pubmed:26987350 |
| Cephalalgia | Decreased levels of aquaporin-4 in the cerebrospinal fluid of patients with idiopathic intracranial hypertension Pubmed:26853804 |
| PLoS One | Cerebrospinal fluid biomarkers of infantile congenital hydrocephalus. pubmed:28212403 |
| Journal of Neurotrauma | Neuron-derived Plasma Exosome Proteins after Remote Traumatic Brain Injury Pubmed: 31441374 |
| Basic and Clinical Neuroscience | Paeonol Protects Against Intrastriatal 6-Hydroxydopamine Rat Model of Parkinson's Disease 33995926 |
| PLoS One | Evaluation of aquaporins in the cerebrospinal fluid in patients with idiopathic normal pressure hydrocephalus 34597351 |
| Catalog No. | Related products for research use of Mus musculus (Mouse) Organism species | Applications (RESEARCH USE ONLY!) |
| RPA582Mu02 | Recombinant Aquaporin 4 (AQP4) | Positive Control; Immunogen; SDS-PAGE; WB. |
| RPA582Mu03 | Recombinant Aquaporin 4 (AQP4) | Positive Control; Immunogen; SDS-PAGE; WB. |
| RPA582Mu01 | Recombinant Aquaporin 4 (AQP4) | Positive Control; Immunogen; SDS-PAGE; WB. |
| PAA582Mu02 | Polyclonal Antibody to Aquaporin 4 (AQP4) | WB |
| PAA582Mu01 | Polyclonal Antibody to Aquaporin 4 (AQP4) | WB; IHC |
| LAA582Mu71 | Biotin-Linked Polyclonal Antibody to Aquaporin 4 (AQP4) | WB; IHC; ICC. |
| MAA582Mu21 | Monoclonal Antibody to Aquaporin 4 (AQP4) | ICC/IF |
| MAA582Mu22 | Monoclonal Antibody to Aquaporin 4 (AQP4) | ICC/IF |
| MAA582Mu23 | Monoclonal Antibody to Aquaporin 4 (AQP4) | ICC/IF |
| LAA582Mu72 | Biotin-Linked Monoclonal Antibody to Aquaporin 4 (AQP4) | WB; IHC; ICC. |
| SEA582Mu | ELISA Kit for Aquaporin 4 (AQP4) | Enzyme-linked immunosorbent assay for Antigen Detection. |
| LMA582Mu | Multiplex Assay Kit for Aquaporin 4 (AQP4) ,etc. by FLIA (Flow Luminescence Immunoassay) | FLIA Kit for Antigen Detection. |
| PSA582Mu01 | Antibody Pair for Aquaporin 4 (AQP4) | ELISA; CLIA; ELISPOT; Luminex; Immunochromatography and other Immunoassays. |
| KSA582Mu01 | ELISA Kit DIY Materials for Aquaporin 4 (AQP4) | Main materials for "Do It (ELISA Kit) Yourself". |